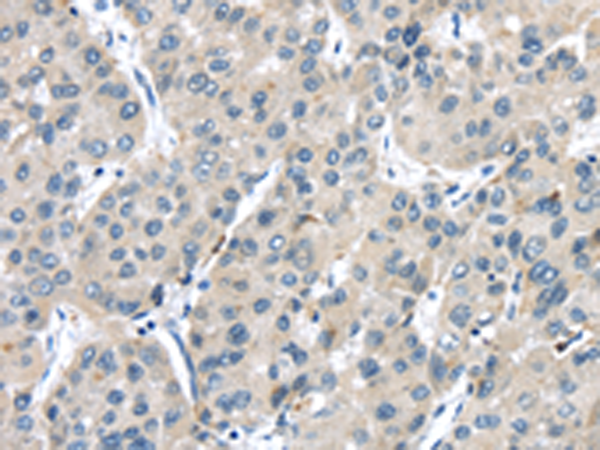

中文名稱: 兔抗TRPM2多克隆抗體
|
Background: |
The protein encoded by this gene is a calcium-permeable cation channel that is regulated by free intracellular ADP-ribose. The encoded protein is activated by oxidative stress and confers susceptibility to cell death. Several alternatively spliced transcript variants of this gene have been described, but their full-length nature is not known. |
|
Applications: |
ELISA, IHC |
|
Name of antibody: |
TRPM2 |
|
Immunogen: |
Fusion protein of human TRPM2 |
|
Full name: |
transient receptor potential cation channel, subfamily M, member 2 |
|
Synonyms: |
KNP3; EREG1; TRPC7; LTRPC2; NUDT9H; NUDT9L1 |
|
SwissProt: |
O94759 |
|
ELISA Recommended dilution: |
2000-5000 |
|
IHC positive control: |
Human liver cancer and human breast cancer |
|
IHC Recommend dilution: |
25-100 |
購(gòu)物車
購(gòu)物車 幫助
幫助
 021-54845833/15800441009
021-54845833/15800441009
